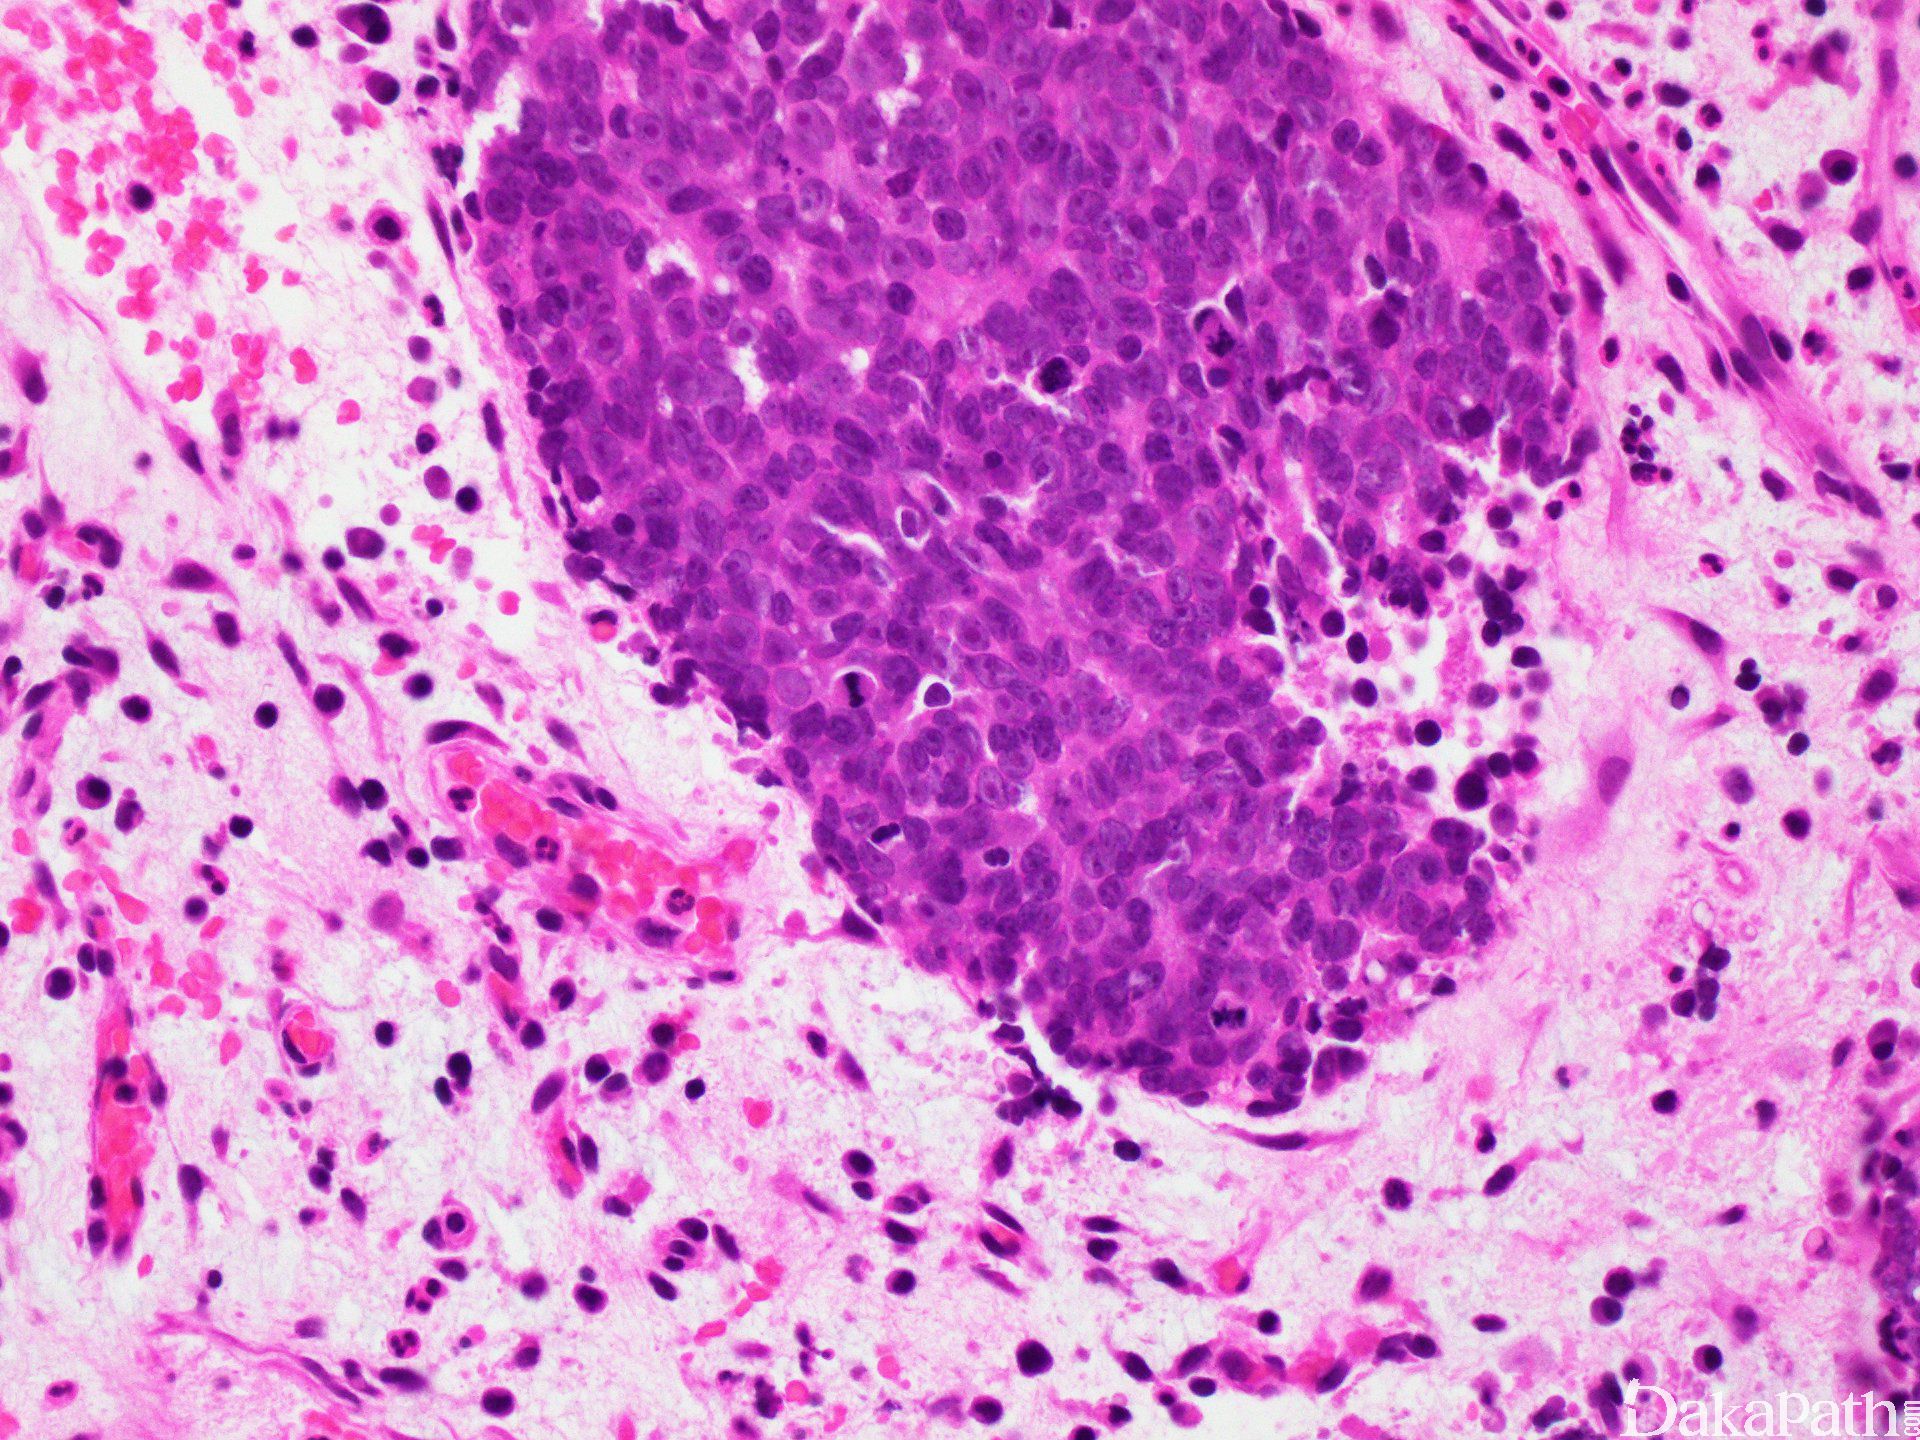

鼻窦未分化癌
Sinonasal Undifferentiated Carcinoma(SNUC)
概述:
一种组织发生不明确的具有高度侵袭的癌,发病过程迅速,由多形细胞组成,频繁出现坏死,未见鳞状及(或)腺样分化的证据,可见神经内分泌分化。
发病部位: 鼻腔、一个或多个副鼻窦、眼眶、颅底及脑。
诊断要点:
不常见,发病年龄 30-90 岁(中位数 60),男性发病多于女性。临床表现鼻塞、鼻出血、眼球突出、视觉障碍,面部疼痛,颅神经累及的症状。
大体上趋于菜花状,浸润 l 邻近组织及骨破坏。肿瘤大小最大径常常超过 4 cm。
镜下肿瘤细胞丰富,呈叶状(器官样)、梁状、实性、片状或带状分布,细胞呈中至大多边形、圆形至卵圆形,核染色深或泡状核,模糊至显著核仁,胞浆多少不等,嗜酸,胞界不清,但部分细胞呈清晰边界,胞浆透明。核浆比高,核分裂像增多,可见非典型核分裂,显著肿瘤坏死及凋亡。
可见淋巴血管浸润及神经侵犯。
可见 3 种细胞类型:
1) Western 型细胞呈圆形至卵圆形、染色深的胞核,小核仁不易察觉,嗜酸性至嗜双色胞浆。
2) 细胞类似于鼻咽未分化癌,包括大的空泡状核、显著核仁,及非肿瘤性淋巴细胞浸润。
3) 大细胞型类似于肺大细胞癌,包括伴有多形性核、显著嗜酸性核仁的大细胞,主要发生于亚洲患者。
未见神经丝样基质或神经菊形团,亦未见鳞状或腺样分化。
很少的病例可出现鳞状分化,但此时需要严格的诊断,临床发病的迅速可能与 SNUC 相关,鳞状灶(角化及间桥)相对比较局限,大部分肿瘤组织显示 SNUC 的特点。未分化癌伴骤然角化提示 NUT 中线癌,应该进行 NUT 蛋白的检测。
免疫组织化学染色:
上皮标记包括 CK-Pan(AE1/AE3, CAM5.2)及简单角蛋白(如 CK7, CK8, and CK19)呈阳性。CK-Pan 一般弥漫强阳性。CK4. CK5/CK6 及 CK14 一般呈阴性。P63 部分病例少量及局灶阳性,部分病例阴性,很少病例呈弥漫阳性,P40 可呈阳性。INI1 核阳性。< 50%病例 EMA、NSE 或 P53 阳性。 S100 很少阳性。Synaptophysin、chromogranin、 CD56. CD57 (Leu-7)局灶阳性。而 Vimentin、calretinin、肌标记 (desmin、myoglobin、myf-4 及 actins) 、造血淋巴标记(LCA 及 B and T cell 相关)、黑色素细胞标记(HMB-45. Melan-A、tyrosinase) 及 CD99 (尤文标记)呈阴性。EBV 的免疫标 记(LMP-1)及(或)原位杂交 EBER 均呈阴性。
鉴别诊断:
嗅神经母细胞瘤**(高级别):(Olfactory Neuroblastoma)NSE 常一致弥漫及强阳性,S100 外周支持细胞阳性。Calretinin 弥漫强阳性,而 SNUCs 局灶阳性。神经内分泌标记(CgA、Syn、CD57 及 CD56)不同程度阳性。CK 阴性或非常局灶阳性,而在 SNUC 弥漫强阳性。
小细胞未分化神经内分泌癌 (Small Cell Undifferentiated Neuroendocrine Carcinoma):神经内分泌标记(chromogranin, synaptophysin, CD57)阳性,而 SNUC 不等量阳性甚至阴性。
非角化鳞状细胞癌 (Squamous Cell Carcinoma, Nonkeratinizing):P16 常阳性,CK5/6. CK13. CK14. P63 阳性,CK7 阴性;而 SNUC 的 CK5/6. CK13. CK14 阴性,CK7 阳性,P63 弱阳性一般呈局灶。
角化鳞状细胞癌 (Squamous Cell Carcinoma, Keratinizing):可见鳞状分化(角化及间桥),高级别上皮内瘤变/原位癌,CK5/6. CK13. CK14. P63 及 P40 阳性;SNUC 的 K5/6. CK13. CK14 阴性,P63 及 P40 弱阳性,一般呈局灶阳性。
黏膜恶性黑色素瘤 (Mucosal Malignant Melanoma):S100. HMB-45. Melan-A 及 tyrosinase 阳性,CK 阴性。
鼻型 NK/T 细胞淋巴瘤 (NK-/T-Cell Lymphoma, Nasal Type):淋巴造血标记(CD45. CD3. CD56 及其他)阳性,CK 阴性,EBER 阳性,P63 可阳性。
横纹肌肉瘤 (Rhabdomyosarcoma):Desmin、muscle specific actin、myoglobin 及 myogenin 阳性,CK 阴性,CD56 及 CD57 可阳性。
NUT 中线癌 (NUT Midline Carcinoma):差分化或未分化伴骤然鳞状分化,大于 80%病例伴有鳞状分化,针对 NUT 蛋白的单克隆抗体弥漫阳性,可见染色体移位,t(15;19)导致 BRD4-NUTM1 融合蛋白产生。
INI1 缺陷癌 (SMARCB1 (INI1) Deficient Carcinoma):比较少见,基底样细胞由大的圆形核,模糊至大核仁,胞浆稀少;横纹肌样细胞伴丰富嗜酸胞浆,呈浆样改变。INI1 免疫阴性。
尤文肉瘤 (PNET/Ewing Sarcoma):FLI-1 (核)and CD99 呈阳性。上皮标记阴性至局灶阳性,可见 t(11;22)(q24;q12)。